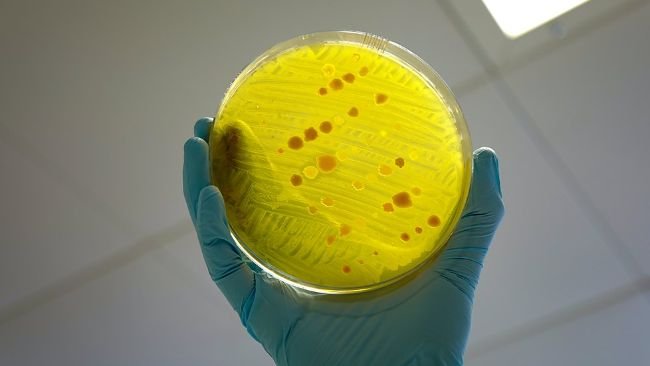

Le Conseil de l'UE adopte une recommandation sur la résistance aux antimicrobiens
La recommandation vise à encourager l'utilisation prudente des antimicrobiens chez les humains et les animaux par une série de mesures volontaires.
Nouvelles, événements et reportages liés au secteur porcin.
Pour se tenir au courant de tous les événements liés au secteur porcin dans le monde
Forum de discussion sur des sujets liés à la production porcine.
Dernières nouvelles de la filière porcine
Un résumé tous les 15 jours des nouveautés de 3trois3.com
Santé porcine : nouvelles et articles sur le SDRP, PCV2, biosécurité, etc., guide des maladies porcines, atlas de pathologie, cas cliniques ...
Comment réaliser une nécropsie sur un porc, étape par étape, de manière très visuelle et pratique.
Description des principales maladies et affections chez le porc
Lésions et signes des principales maladies du porc
Toutes les informations sur la peste porcine africaine (3trois3 et liens externes).
Calcule la quantité de médicament à incorporer quand on utilise une pompe doseuse
Un résumé tous les 15 jours des nouveautés de 3trois3.com
Cours du porc par pays. Production et commerce de viande. Nouvelles des marchés du porc et des matières premières.
Derniers cours des marchés du porc les plus importants. Prix historiques en différentes devises; avec des cours de change en temps réel
Dernières cotations des principales découpes de viande de porc. Historique des prix en différentes devises et au format graphique.
Données et tendances des effectifs, de la production de viande, du commerce...
Données sur la production et le commerce mondial des principales matières premières
Un résumé tous les 15 jours des nouveautés de 3trois3.com
Articles sur la nutrition et l'alimentation des porcs, caractéristiques des matières premières et des additifs et prix des matières premières.
Données sur la production et le commerce mondial des principales matières premières
Utilisez cet outil pour diagnostiquer les problèmes d'indice de consommation. Cliquez sur le diagramme ou sur les boutons dans le texte pour naviguer dans les différentes parties de l'outil.
Un résumé tous les 15 jours des nouveautés de 3trois3.com
Articles sur la génétique et la reproduction porcine : sélection génétique, génomique, insémination artificielle, utilisation d'hormones ...
Compare données de production, calcule le nombre de places pour truies, post-sevrage et engraissement et montre vos tâches en fonction de chaque type de CEB
Simulateur pour calculer les entrées de truies en démarrant un élevage, en l'agrandissant ou pour calculer le renouvellement d'un élevage en activité.
Un résumé tous les 15 jours des nouveautés de 3trois3.com
Gestion et conduite des élevages porcins et organisation du travail dans chacune des phases de production : conduite en gestation, engraissement, conduite e
Compare données de production, calcule le nombre de places pour truies, post-sevrage et engraissement et montre vos tâches en fonction de chaque type de CEB
Un résumé tous les 15 jours des nouveautés de 3trois3.com
Conception d'installations et d'équipements pour les élevages de porcs: conception des salles, climatisation, systèmes d'alimentation, etc. comparateurs d'é
Calculateur d'empreinte environnementale tout au long de la chaîne de valeur de la filière porcine
Un résumé tous les 15 jours des nouveautés de 3trois3.com

La recommandation vise à encourager l'utilisation prudente des antimicrobiens chez les humains et les animaux par une série de mesures volontaires.

La résistance aux antimicrobiens figure parmi les trois principales menaces sanitaires prioritaires dans l'UE.

Cette baisse a été rendue possible par diverses initiatives sectorielles visant à réduire l'utilisation d'antibiotiques chez les animaux d'élevage.

Depuis 2011, les entreprises pharmaceutiques et les grossistes sont tenus de déclarer la quantité d'antibiotiques qu'ils ont fournie aux vétérinaires en Allemagne.

Pour la première fois, l'Espagne, la France et le Portugal présentent des résultats à la recherche d'une solution au problème de la disponibilité des antimicrobiens et de leurs alternatives en médecine vétérinaire.

Conclusions du rapport de synthèse de l'Union européenne sur la résistance aux antimicrobiens des bactéries zoonotiques et indicatrices présentes chez les humains, chez les animaux et dans les denrées alimentaires en 2020/2021.

Les dernières données révèlent que les résidus de médicaments vétérinaires et d'autres substances présents chez les animaux et dans les denrées alimentaires d'origine animale continuent de diminuer dans l'UE et que les niveaux de conformité augmentent.
Le volume des ventes d’antibiotiques entre 2020 et 2021 a diminué.

Pour l'ensemble de la période 2011-2021, les ventes générales d'antibiotiques vétérinaires ont diminué de 47 %, atteignant la valeur la plus faible jamais observée.

Le Comité des Médicaments Vétérinaires a proposé un nouveau groupe de travail pour remplacer le réseau volontaire de surveillance de la consommation d'antimicrobiens vétérinaires.

L'EFSA a publié un avis scientifique évaluant le risque de propagation de la résistance antimicrobienne dans le transport des porcs entre les élevages ou vers les abattoirs.

Le gouvernement fédéral allemand a adopté un projet de loi visant à modifier la loi sur les médicaments vétérinaires.

La vente de médicaments vétérinaires contenant ces antimicrobiens est interdite.

Un rapport de l’Organisation mondiale de la santé animale met en évidence des tendances prometteuses dans la lutte contre la résistance aux antimicrobiens et la préservation de l’efficacité de ces médicaments essentiels.

L'étude donne un aperçu de la situation en matière de bien-être animal et d'utilisation des antimicrobiens dans l'UE.

Lancement d'un nouveau portail web ActionAntibio dédié aux actions EcoAntibio dans les filières animales afin de lutter contre l'antibiorésistance.